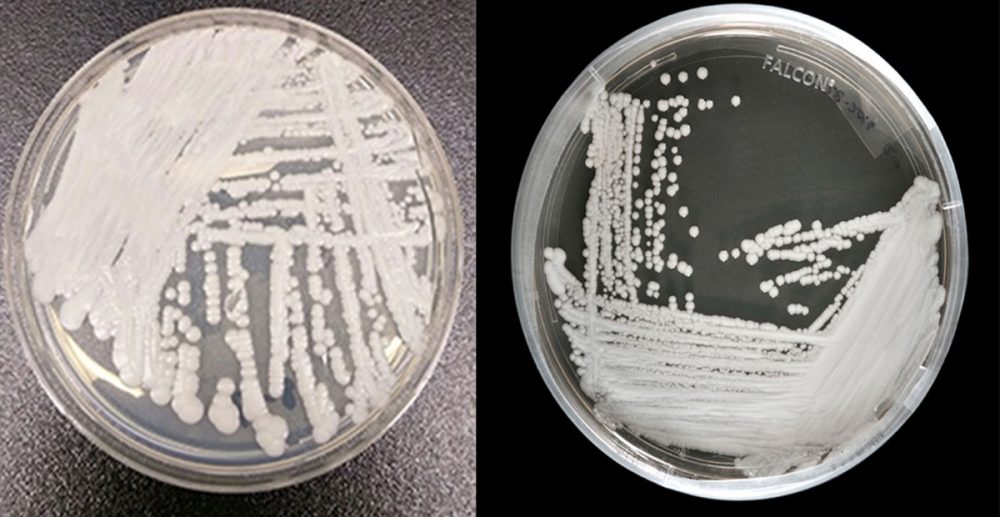
candida auris

En los últimos días ha surgido una enfermedad que ha puesto en jaque a científicos…
virus
La Nueva variante del Covid-19 ya se encuentra en más partes del mundo. Ómicron es…
África confirmó la primera muerte a causa del virus Marburgo, proveniente de la misma familia…
A lo largo de la historia, los diferentes virus que han existido han ayudado a…
Algunas películas que se estrenaron hace casi 10 años, pareciera que hoy se han convertido…
Dentro de lo que es la seguridad de un dispositivo tecnológico o específicamente hablando computadoras,…
Los equipos de computo de edificios administrativos de Petróleos Mexicanos así como en una serie…
Candida Auris, un virus mortal que se propaga rápidamente por varios países del mundo, fue…
Desde hace algunos días se viene escuchando sobre un virus malicioso, que se filtra a…
Aunque sea muy repetitivo, tenemos que insistir en la seguridad de nuestros dispositivos, los virus…
En nuestro querido México y otros paises para atacar equipos de computo se acostumbra a…
El pasado 19 de enero se celebraron los primeros 25 años de que naciera el…